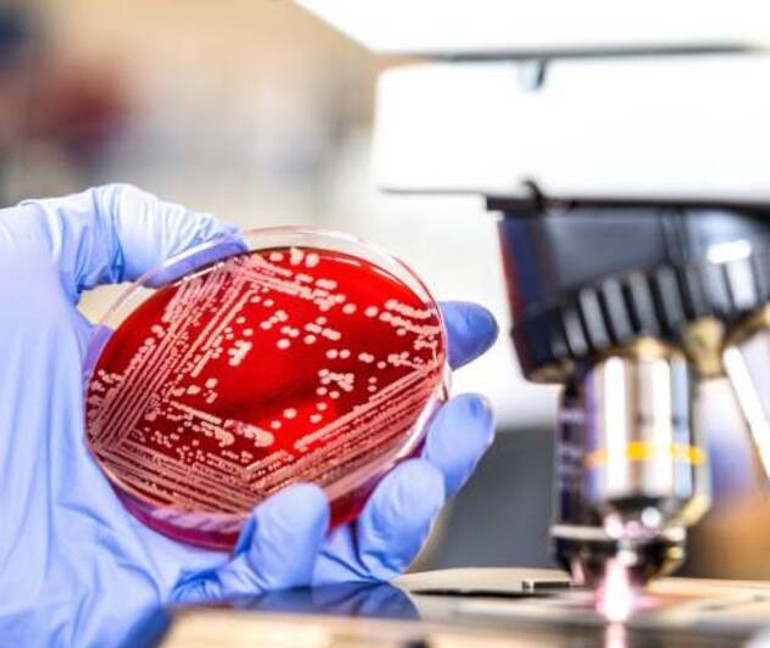
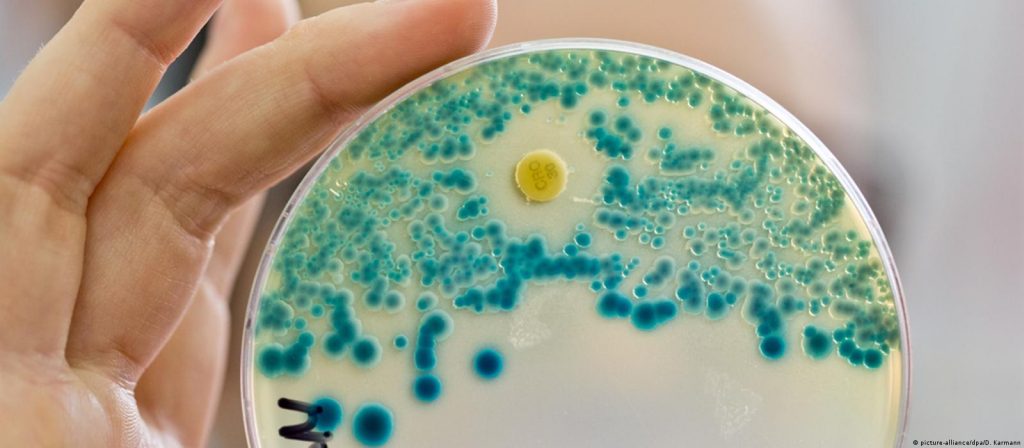

Винахід антибіотиків став величезним досягненням XX століття, завдяки якому вдалося врятувати мільйони життів. Однак на сьогодні цей прогрес знаходиться під загрозою — з часом бактерії набувають стійкості до антибіотиків, що ставить під сумнів ефективність сучасного лікування інфекцій.
За даними Всесвітньої організації охорони здоров’я (ВООЗ), щорічно від інфекцій, що стали стійкими до ліків, помирає близько 700 тисяч людей у світі.
«Навіть найпоширеніші інфекції стало складніше лікувати»
Цю проблему детально пояснює Наталія Семуха, лікар-терапевт терапевтичного відділення Міської клінічної лікарні №4 у Дніпрі, яка наголошує на тому, що стійкість до антибіотиків стає все більш очевидною:
«Ми все частіше виявляємо стійкість до антибіотиків у пацієнтів».
Причини антибіотикорезистентності
Однією з основних причин розвитку антибіотикорезистентності є нераціональне використання антибіотиків.
Це включає:
-
Самолікування, зокрема застосування антибіотиків при вірусних інфекціях, на які ці препарати не діють.
-
Прийом ліків на основі порад знайомих.
-
Профілактичне використання антибіотиків під час сезонних захворювань (грип, ГРВІ) чи загострення хронічних недуг.
Зокрема, на поширення стійкості значно вплинули пандемія COVID-19 та війна, адже за останні роки люди безсистемно приймали величезну кількість антибіотиків.
Також важливим фактором є використання антибіотиків у тваринництві, що призводить до забруднення м’яса антибіотиками, які потрапляють у наш організм через їжу.
Радимо також прочитати: Антибіотики для дітей: суспензія, капсули чи таблетки – що краще?
Наслідки антибіотикорезистентності: чому це небезпечно?
Наявність стійких до антибіотиків інфекцій робить лікування значно складнішим. Тривалість госпіталізації зростає, а лікування триває вдвічі довше.
«Візьмемо для прикладу бактеріальну пневмонію. Якщо раніше лікування тривало 5-7 днів, то зараз може знадобитися два чи навіть три тижні», — пояснює Наталія Семуха.
Зростає і навантаження на систему охорони здоров’я. Лікування таких пацієнтів потребує значно більше ресурсів, включаючи додаткові медичні працівники, посилене навантаження на лабораторії та стаціонари. Зокрема, все більше пацієнтів страждають від мультирезистентних інфекцій, коли бактерії стійкі до кількох препаратів одночасно. В таких випадках пацієнтів потрібно ізолювати в окремих палатах.
«Випадки мультирезистентності зустрічаються майже кожного дня у нашій практиці. Багато складних випадків, за яких постає питання, як краще працювати, бо рекомендації та протоколи не діють», — зазначає експерт.
Супербактерії: глобальна загроза
З серйозною проблемою стикаються лікарі при панрезистентності — коли бактерії не реагують на жоден антибіотик. В таких випадках лікування стає неможливим.
«Наразі йдеться про поодинокі випадки панрезистентності. У нашій лікарні з таким викликом ще не зіштовхувалися. Однак це справді серйозна проблема, адже немає препаратів, якими можна вилікувати людину з супербактерією. Ймовірність смерті значно зростає, і це найгірше», — зазначає Наталія Семуха.

Що можна зробити, щоб змінити ситуацію?
-
Не використовуйте антибіотики для лікування вірусних інфекцій, таких як нежить чи кашель. Вони не мають ефекту при таких захворюваннях.
-
Не приймайте препарати за порадою знайомих, оскільки це може призвести до неправильного лікування та розвитку стійкості.
-
Дотримуйтесь правильної схеми прийому антибіотиків, яку призначив лікар, і не зупиняйте лікування до завершення курсу, навіть якщо ви почуваєтеся краще.
-
Зміцнюйте імунітет через здоровий спосіб життя, збалансовану дієту та фізичні вправи.
«Якнайперше, не лікуйте нежить, кашель чи будь-яку вірусну інфекцію антибіотиками та не приймайте препарати за рецептом знайомих», — підкреслює Наталія Семуха.
Радимо також прочитати: Антибіотики взимку: чому це може бути небезпечніше, ніж здається?